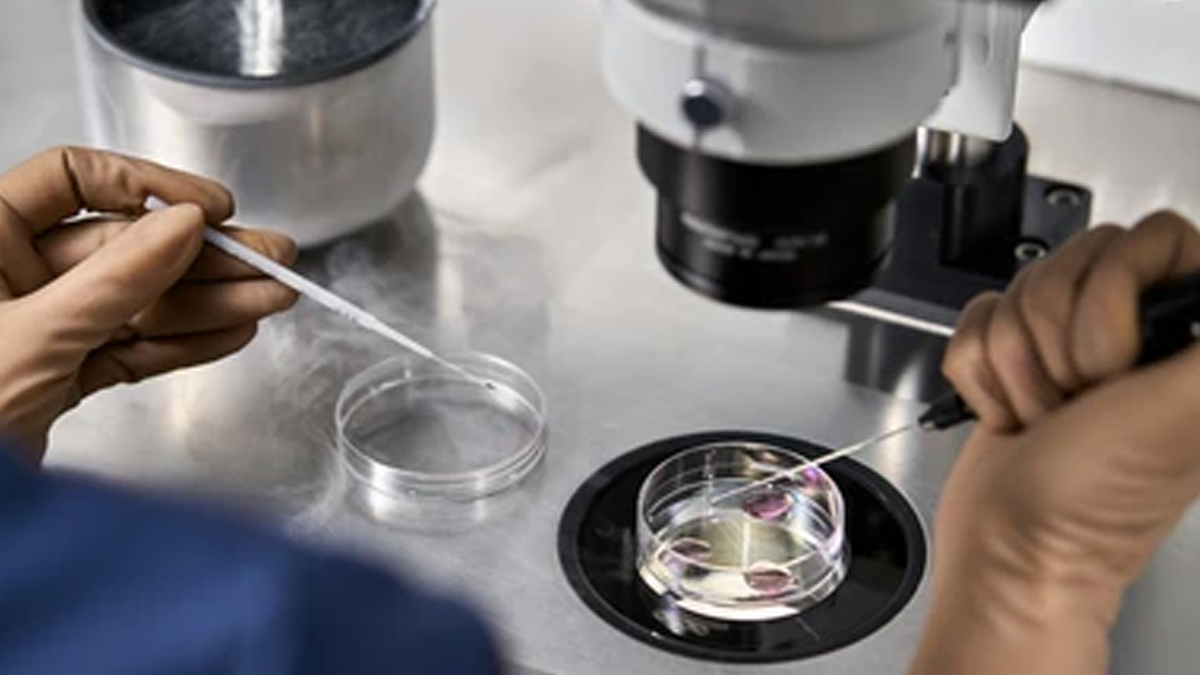

Egg reserve or also known as ovarian reserve, is a critical factor when it comes to a woman’s fertility. As women age, their egg reserve naturally declines, which is why fertility typically starts to decrease in the early 30s and accelerates after age 35. However, some women experience a faster decline than others. Can this happen? Dr Anjali Kumar, aka Maitri Woman on Instagram, recently shared important insights that yes it is possible and talked about the signs of a faster-than-normal egg reserve decline, and how you can recognise them.
Causes Of Premature Decline of Egg Reserve
Declining egg reserve, or Diminished Ovarian Reserve (DOR), is primarily caused by natural ageing, as women are born with a finite number of eggs. Other factors include genetic predispositions, medical treatments like chemotherapy or radiation, conditions such as endometriosis or PCOS, lifestyle choices like smoking or high stress, and exposure to environmental toxins.
Signs Of Declining Egg Reserve
Dr Kumar, an expert in women’s health and wellness, took to her Instagram platform to talk about women and the key signs that could indicate a rapid decrease in egg reserve. These signs, though often subtle, can provide important clues for those trying to conceive or maintain optimal fertility. Let's understand what these signs are and what they could mean for your health.

Also Read: The Rise Of Vaginal Birth After Caesarean (VBAC): What Every Mother Needs To Know
1. Irregular or Missed Periods
One of the earliest signs of egg reserve decline is irregular or missed periods. As women age and their egg count reduces, hormonal imbalances tend to interfere with the regularity of menstruation. Dr Kumar explains that a consistent cycle may begin to change, making periods less predictable. This can be a red flag that egg reserve is decreasing and may suggest that the ovaries are producing fewer eggs. Thus, if you're noticing that your period is either coming too early, too late or skipping altogether, it might be worth discussing with your gynaecologist to monitor your ovarian health more closely.
2. Hot Flashes or Night Sweats
Hormonal fluctuations due to a reduced egg reserve can trigger symptoms like hot flashes and night sweats. Dr Kumar emphasises that these symptoms, commonly associated with menopause, can also occur in women who are experiencing early signs of a faster egg reserve decline. The hormonal shifts that occur when egg production slows down can lead to an increase in body temperature, resulting in sudden feelings of warmth, sweating, and discomfort.
3. Fatigue and Low Energy
If you’ve been feeling unusually tired or lacking in energy, your egg reserve may be trying to tell you something. A decline in egg reserve can affect more than just your reproductive system—it can disrupt your overall well-being. According to Dr Kumar, hormonal changes associated with egg reserve decline can lead to fatigue, poor sleep quality, and a general sense of low energy. This can be triggered by stress or other lifestyle factors, but if you're finding that your energy levels are consistently low despite a healthy lifestyle, it might be worth consulting a specialist.
Also Read: The Rise Of Vaginal Birth After Caesarean (VBAC): What Every Mother Needs To Know
4. Trouble Conceiving
Struggling to conceive can be one of the most frustrating signs that your egg reserve may be declining. Dr Kumar highlights that even if a woman’s cycle is regular, an insufficient egg reserve can significantly hinder the ability to conceive. Women with a low egg count may experience difficulty in achieving pregnancy, and this can become more pronounced with age. If you’ve been trying to conceive for over six months without success, it’s recommended to speak with a fertility expert who can assess your ovarian reserve through tests like an ultrasound or blood work.
5. Family History of Early Menopause
Family history plays a key role in determining when your egg reserve might start to decline. Dr Kumar points out that if your mother or grandmother experienced early menopause, there is a higher likelihood that you may too. Genetic factors can impact the timing of egg depletion, making it important to understand your family’s reproductive history.
What Can You Do?
If you notice any of these signs, don’t panic—there are steps you can take. Dr Kumar recommends seeking professional advice if you're concerned about your egg reserve. Testing and screenings can help give you a clearer picture of your reproductive health and help you make informed decisions about fertility. Additionally, maintaining a healthy lifestyle such as eating well, managing stress, exercising, and avoiding smoking can support reproductive health.
Bottomline
While some factors, like genetics, are out of your control, being proactive about your fertility health can empower you to take charge of your future. Remember, fertility is a deeply personal and complex journey, and no two women experience it in the same way. Whether you’re just starting to think about family planning or have been struggling to conceive, know that support, knowledge, and options are available.
How we keep this article up to date:
We work with experts and keep a close eye on the latest in health and wellness. Whenever there is a new research or helpful information, we update our articles with accurate and useful advice.
Current Version